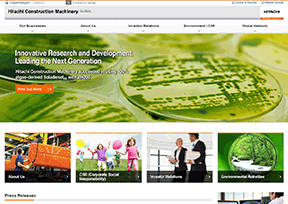

网站大全

-
日本Sunrise_日升动画
更新日期:2021-04-22 19:26:44
株式会社日昇(Sunrise)是日本的一家娱乐公司,成立于1972年,总部位于东京,主要从事动画制作,其作品包括《机动战士高达》系列、《城市猎人》系列、《银魂》系列、《犬夜叉》等。...

-
日本爱之风富山铁道
更新日期:2021-04-22 19:26:53
爱之风富山铁道(Ainokaze Toyama Railway)是日本的一家铁路公司,成立于2012年,总部位于富山县富山市,主要经营铁路客运业务。爱之风富山铁道公司官网提供有线路图、沿线指南、时刻表等内容...

-
日本福岛县立医科大学
更新日期:2021-04-22 19:26:51
福岛县立医科大学(Fukushima Medical University)是日本的一所公立大学,创建于1944年,位于福岛县福岛市,设有医学部和看护学部。...
-
日本日立建机
更新日期:2021-04-22 19:26:54
日立建机株式会社(Hitachi Construction Machinery)为 日立 制作所子公司,全球最大的工程机械制造商之一,成立于1970年,总部位于东京。日立建机主要产品包括挖掘机、装载机,经销网络遍布全球...

-
日本吉野家
更新日期:2021-04-22 19:26:55
吉野家(Yoshinoya)是日本著名快餐连锁品牌,成立于1899年,总部位于东京,在中国、新加坡、马来西亚等国拥有超过1700间分店。...

-
日本日本安立公司
更新日期:2021-04-22 19:26:56
安立公司(Anritsu)是日本的一家通信解决方案供应商,成立于1895年,总部位于神奈川县。安立公司主要生产测试仪器、工业机械、元器件等,包括无线通信测试设备、微波\射频测试设备、光通...

-
日本泰尔茂株式会社
更新日期:2021-04-22 19:26:57
泰尔茂株式会社(Terumo Corporation)日本医疗器械和医药制品供应商,于1921年创建,总部位于东京都涩谷区,主要提供一次性医用器械、输血用具、医药品和营养药、血管造影与治疗导管、医用...

-
日本日本学习院大学
更新日期:2021-04-22 19:26:58
学习院大学(Gakushuin University)是日本的一所私立大学,始建于1877年,位于东京都丰岛区,开设有法学、经济学、文学、理学等学部。在2015年QS亚洲大学排名中,学习院大学排在第161-170位。...

-
日本拓殖大学
更新日期:2021-04-22 19:26:59
拓殖大学(Takushoku University)是日本的一所私立大学,创建于1922年,在东京都文京区和八王子市拥有两个校区,开设有政经学部、商学部、外国语学部等学部。...

-
日本馥兰皙儿
更新日期:2021-04-22 19:27:00
馥兰皙儿(BLANCHIR SUPERIOR)是日本 佳丽宝(Kanebo)集团 旗下主推美白护肤的品牌,也是日本美白护肤的领导品牌,于1989年创立,旨在为东方女性打造净透美肌。经过多年研究,佳丽宝发现了红...


